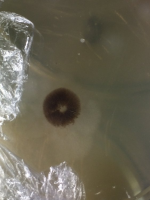
image.png
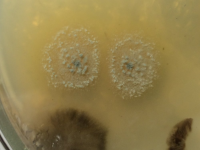
image.png

Привет всем кому интересна тема склерообразующих видов грибов!
Тампаненсис-один из них,одинаково хорошо может растить и склеротии ,которые называют пси-трюфеля,камни силы,камни философии .,так же и сами Грибы ,то есть грибные тела !
Это продолжение репорта https://hit.ganjalive.city/topic/28223-podem-mitceliia-tampanensisov-skleroobrazuiuschij-vidplody-poluchenyotpechatki-polucheny/
Решил не сваливать все в одну ,а немного разделить их
Что я сделал уже для этого репортажа?
Сварил агар ,немного прокипятил ложку зерна пшеницы,ложку овса нешелушенного ,добавил на 100 грамм воды 3 грамма агара ,обычного пищевого (кондитерского ).
Когда он застыл положил на него в чп шляпку , таким образом "посредник " отсутствует ) Сразу споры от носителя на питательный субстрат

и две половинки на следущую чп

И одна чп была засеяна кусочками ножки (ножки были максимально распотрашены и взят материал со срединки,) перед агаром макнул их в перекись-как раз гляну убил не убил их раствор
Общий вид и вид кусочком ножек

Тампаненсис-один из них,одинаково хорошо может растить и склеротии ,которые называют пси-трюфеля,камни силы,камни философии .,так же и сами Грибы ,то есть грибные тела !
Это продолжение репорта https://hit.ganjalive.city/topic/28223-podem-mitceliia-tampanensisov-skleroobrazuiuschij-vidplody-poluchenyotpechatki-polucheny/
Решил не сваливать все в одну ,а немного разделить их
Что я сделал уже для этого репортажа?
Сварил агар ,немного прокипятил ложку зерна пшеницы,ложку овса нешелушенного ,добавил на 100 грамм воды 3 грамма агара ,обычного пищевого (кондитерского ).
Когда он застыл положил на него в чп шляпку , таким образом "посредник " отсутствует ) Сразу споры от носителя на питательный субстрат

и две половинки на следущую чп

И одна чп была засеяна кусочками ножки (ножки были максимально распотрашены и взят материал со срединки,) перед агаром макнул их в перекись-как раз гляну убил не убил их раствор
Общий вид и вид кусочком ножек

хотелось узреть!



























